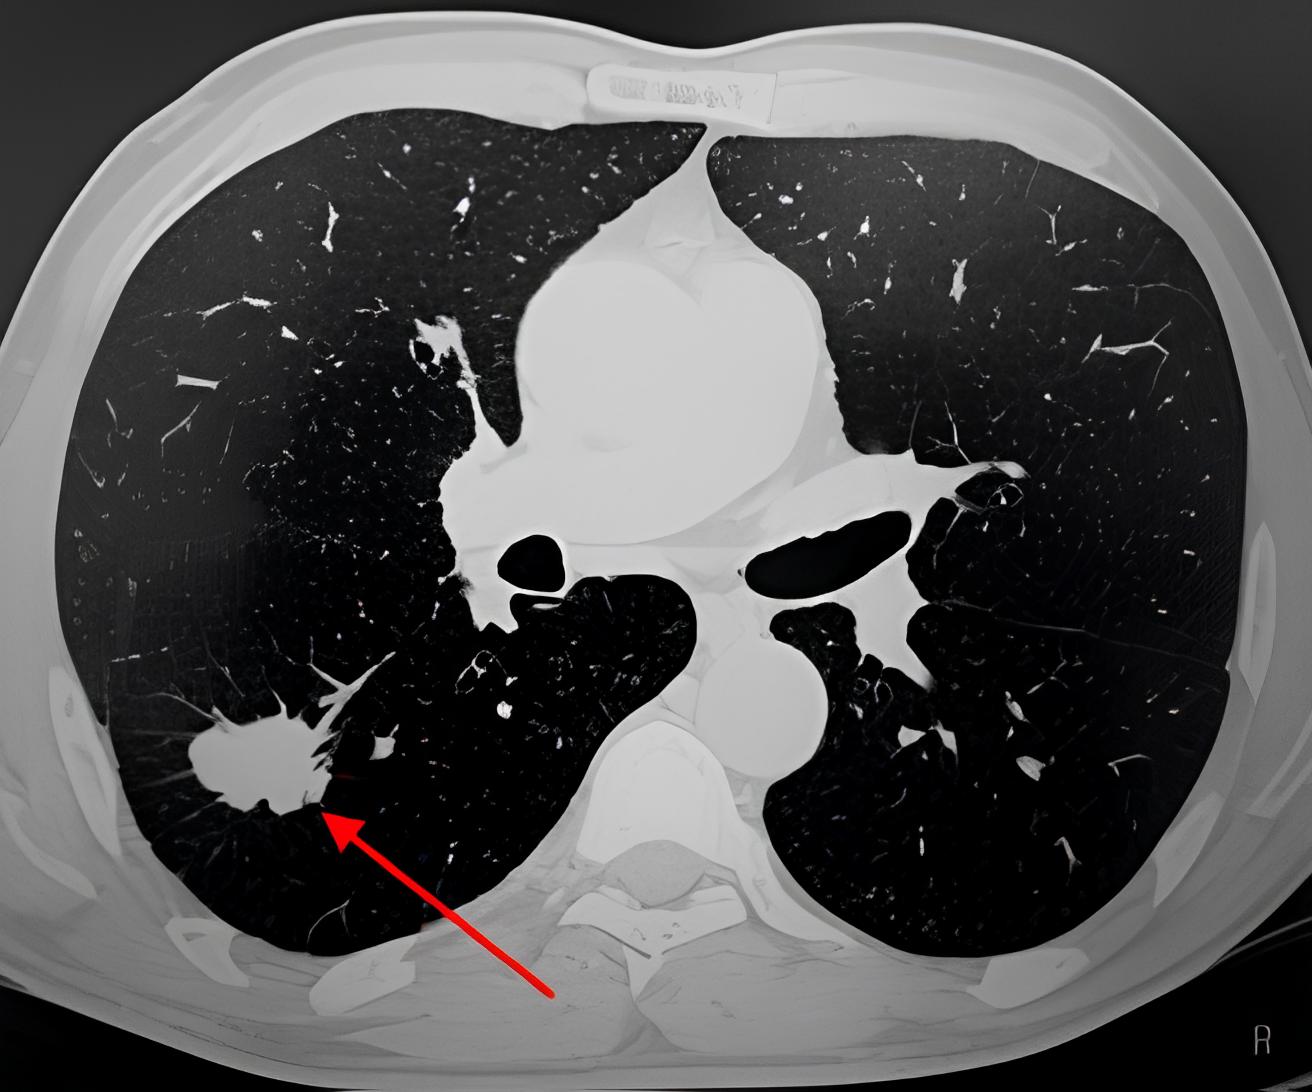

Форум после кт
Solutions intermediate student s book answers
Шипучие витамины для похудения
Варить в крутую
А у тебя что есть сестра
Полное богородичное правило с тропарями
Агутин ты когда нибудь меня простишь текст
Знание и его способности
Ментальная связь на расстоянии это
Швабра takara
День авиации 18 августа картинки
Дари отвергнутая невеста
Упражнение брандт дарофф видео уроки
Как все хорошо получилось
Форум после кт 80 фото